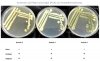
ID 2.jpg

Du verwendest einen veralteten Browser. Es ist möglich, dass diese oder andere Websites nicht korrekt angezeigt werden.
Du solltest ein Upgrade durchführen oder einen alternativen Browser verwenden.
Du solltest ein Upgrade durchführen oder einen alternativen Browser verwenden.
G
Gelöschtes Mitglied 9419
Guest
Hallo
Dieser Winter ist wirklich speziell oder er hat noch gar nicht begonnen!? Die Temperaturen meines Teichwassers verweilten in den vorgängigen Herbstzeiten jeweils ca. einen Monat um die 10°C, bis sie wieder deutlich sanken. In der aktuellen Jahreszeit hatte ich jedoch bereits an fast 90 aufeinander folgenden Tagen, Temperaturen knapp tiefer 10°C gemessen.
Dies ist aussergewöhnlich und hatte prompt zu einer Verschiebung der Bakterienanteile innerhalb dieser Zeitspanne geführt. Zwar zeigte sich die Höhe der GKZ mit durchschnittlich 1‘400 KBE/ml im gewohnten Rahmen, jedoch verdoppelte sich die Zahl der Pseudomonaden auf 600 KBE/ml. Kein Grund für schlaflose Nächte aber für mich doch Anlass diese Besucher wieder einmal näher kennen zu lernen.
Ich untersuchte meine bewachsenen Platten genauer um diese Keime mit der „bunten Reihe“ oder ähnlichen Systemen zu identifizieren. Für die Dokumentation dieser Arbeiten habe ich einen Dip Slide ausgewählt, der als Beispiel und Ausgangspunkt für die beschriebenen Tätigkeiten stehen soll.
Wenn der Tauchnährboden mit Bakterien bewachsen ist stellt man meistens fest, dass nicht alle Kolonien gleich aussehen. Darum ist ein genauer Beschrieb dieser „Pickel“ wichtig, denn einige Bakteriengruppen lassen sich bereits nach dem Aussehen der Kolonien bestimmen. Ich denke hier an die aeroben Sporenbildner oder an den einten oder anderen Hefepilz. Auch wird das Aussehen oder die Beschaffenheit der Kolonie im lateinischen Namen des Bakteriums meistens wiedergegeben. „Licheniformis“ zum Beispiel bedeutet „flechtenbildend“ worauf sich die Kolonie als hartnäckige Kruste präsentiert, die sich kaum unversehrt vom Nährboden entfernen lässt oder das Wort „Bacillus“ das sich auf die Stäbchenform der Bakterienzelle bezieht. Letzteres ersichtlich bei der Mikroskopie.
Um bei der Identifikation verlässliche Ergebnisse zu erhalten, ist es sehr wichtig den Bakterienbewuchs weiter zu ziehen um Reinkulturen zu erhalten. Dazu wird ein geeigneter Ausstrich angewendet, um die womöglich überwachsene Platte in Einzelkolonien zu trennen.
Beim Mikroskopieren wird die Form der Bakterienzelle erkannt, wobei es zwei Grundformen gibt. Die Kokken und Stäbchen die jedoch in verschiedenen Anordnungen auftreten können. So gibt es einzelne-, zweier-Kokken, vierer Pakete, klebrige Haufen, kurze- oder lange Ketten usw. Das gleiche zeigt sich in etwa bei den Stäbchen wo es auch sehr unterschiedliche und unregelmässige Erscheinungen wie z.B. spiralförmig gedreht oder Y-psilon Formen gibt. Die Grundform ist aber meistens deutlich zu erkennen. Wenigen Bakterien ist es auch möglich während der Kultivierung ihre Grundform zu ändern.
Vor oder nach der Festlegung des mikroskopischen Befundes, wird beim Bakterium die Beschaffenheit der Zellwand mittels einer Bakterienfärbung und die Reaktionen zweier Enzyme abgeklärt, die für die Art der Identifikation wegweisend sind. So wird die Zellwand mit Gram + oder – unterschieden. Die Reaktion der Oxidase ist meistens hilfreich bei der Trennung von Enterobakterien und Pseudomonaden und die Katalase zeigt z.B. ob es sich um Streptokokken oder Staphylokokken handelt. Wichtige Informationen die schon viel „Klärendes“ mit sich bringen und die Auswahl des Materials zur Identifikation erleichtern. Bei Systemen wie der „bunten Reihe“ gibt es solche für Gram negative- wie positive Keime, solche die der Oxidasereaktion entsprechen oder einfach einer Bakteriengruppe.
Wurde die Reinkultur herangezüchtet wird sie mit einer Flüssigkeit vermischt, worauf jede Kammer der „bunten Reihe“ mit dieser Suspension versetzt wird. Bakterien können verschiedenste Stoffe verarbeiten oder eben nicht. Darum ist jede Kammer mit einer anderen Substanz befüllt. Meistens sind dies verschiedene Proteine, Zucker oder Säuren.
Beim „verstoffwechseln“ der Bakterien bei vorgegebener Inkubations-Temperatur und Zeit, werden die jeweiligen Reaktionen in den Kammern mit einem Farbumschlag angezeigt. Diese Farbveränderungen ergeben ein Profil mit einem Zahlencode, der mit einer Datenbank verglichen wird und schlussendlich einem Bakterium zugeordnet werden kann.
Da diese Werte mit einer Datenbank verglichen werden, wird das Resultat bei solchen Identifikationssystemen nie mit 100 % iger Sicherheit angegeben. Es ergeben sich jedoch Wahrscheinlichkeiten bis zu 99.9%.
Dieser Winter ist wirklich speziell oder er hat noch gar nicht begonnen!? Die Temperaturen meines Teichwassers verweilten in den vorgängigen Herbstzeiten jeweils ca. einen Monat um die 10°C, bis sie wieder deutlich sanken. In der aktuellen Jahreszeit hatte ich jedoch bereits an fast 90 aufeinander folgenden Tagen, Temperaturen knapp tiefer 10°C gemessen.
Dies ist aussergewöhnlich und hatte prompt zu einer Verschiebung der Bakterienanteile innerhalb dieser Zeitspanne geführt. Zwar zeigte sich die Höhe der GKZ mit durchschnittlich 1‘400 KBE/ml im gewohnten Rahmen, jedoch verdoppelte sich die Zahl der Pseudomonaden auf 600 KBE/ml. Kein Grund für schlaflose Nächte aber für mich doch Anlass diese Besucher wieder einmal näher kennen zu lernen.
Ich untersuchte meine bewachsenen Platten genauer um diese Keime mit der „bunten Reihe“ oder ähnlichen Systemen zu identifizieren. Für die Dokumentation dieser Arbeiten habe ich einen Dip Slide ausgewählt, der als Beispiel und Ausgangspunkt für die beschriebenen Tätigkeiten stehen soll.
Wenn der Tauchnährboden mit Bakterien bewachsen ist stellt man meistens fest, dass nicht alle Kolonien gleich aussehen. Darum ist ein genauer Beschrieb dieser „Pickel“ wichtig, denn einige Bakteriengruppen lassen sich bereits nach dem Aussehen der Kolonien bestimmen. Ich denke hier an die aeroben Sporenbildner oder an den einten oder anderen Hefepilz. Auch wird das Aussehen oder die Beschaffenheit der Kolonie im lateinischen Namen des Bakteriums meistens wiedergegeben. „Licheniformis“ zum Beispiel bedeutet „flechtenbildend“ worauf sich die Kolonie als hartnäckige Kruste präsentiert, die sich kaum unversehrt vom Nährboden entfernen lässt oder das Wort „Bacillus“ das sich auf die Stäbchenform der Bakterienzelle bezieht. Letzteres ersichtlich bei der Mikroskopie.
Um bei der Identifikation verlässliche Ergebnisse zu erhalten, ist es sehr wichtig den Bakterienbewuchs weiter zu ziehen um Reinkulturen zu erhalten. Dazu wird ein geeigneter Ausstrich angewendet, um die womöglich überwachsene Platte in Einzelkolonien zu trennen.
Beim Mikroskopieren wird die Form der Bakterienzelle erkannt, wobei es zwei Grundformen gibt. Die Kokken und Stäbchen die jedoch in verschiedenen Anordnungen auftreten können. So gibt es einzelne-, zweier-Kokken, vierer Pakete, klebrige Haufen, kurze- oder lange Ketten usw. Das gleiche zeigt sich in etwa bei den Stäbchen wo es auch sehr unterschiedliche und unregelmässige Erscheinungen wie z.B. spiralförmig gedreht oder Y-psilon Formen gibt. Die Grundform ist aber meistens deutlich zu erkennen. Wenigen Bakterien ist es auch möglich während der Kultivierung ihre Grundform zu ändern.
Vor oder nach der Festlegung des mikroskopischen Befundes, wird beim Bakterium die Beschaffenheit der Zellwand mittels einer Bakterienfärbung und die Reaktionen zweier Enzyme abgeklärt, die für die Art der Identifikation wegweisend sind. So wird die Zellwand mit Gram + oder – unterschieden. Die Reaktion der Oxidase ist meistens hilfreich bei der Trennung von Enterobakterien und Pseudomonaden und die Katalase zeigt z.B. ob es sich um Streptokokken oder Staphylokokken handelt. Wichtige Informationen die schon viel „Klärendes“ mit sich bringen und die Auswahl des Materials zur Identifikation erleichtern. Bei Systemen wie der „bunten Reihe“ gibt es solche für Gram negative- wie positive Keime, solche die der Oxidasereaktion entsprechen oder einfach einer Bakteriengruppe.
Wurde die Reinkultur herangezüchtet wird sie mit einer Flüssigkeit vermischt, worauf jede Kammer der „bunten Reihe“ mit dieser Suspension versetzt wird. Bakterien können verschiedenste Stoffe verarbeiten oder eben nicht. Darum ist jede Kammer mit einer anderen Substanz befüllt. Meistens sind dies verschiedene Proteine, Zucker oder Säuren.
Beim „verstoffwechseln“ der Bakterien bei vorgegebener Inkubations-Temperatur und Zeit, werden die jeweiligen Reaktionen in den Kammern mit einem Farbumschlag angezeigt. Diese Farbveränderungen ergeben ein Profil mit einem Zahlencode, der mit einer Datenbank verglichen wird und schlussendlich einem Bakterium zugeordnet werden kann.
Da diese Werte mit einer Datenbank verglichen werden, wird das Resultat bei solchen Identifikationssystemen nie mit 100 % iger Sicherheit angegeben. Es ergeben sich jedoch Wahrscheinlichkeiten bis zu 99.9%.
Anhänge
G
Gelöschtes Mitglied 9419
Guest
G
Gelöschtes Mitglied 9419
Guest
G
Gelöschtes Mitglied 9419
Guest
Um auf die Pseudomonasbelastung meines Teichwassers zurück zu kommen, kann ich berichten dass die Kälteperiode Mitte Januar den unbeheizten Teich wenige Tage auf 2°C gekühlt hatte und ich danach in meinen Unterlagen einen Wert tiefer 10 KBE/ml notieren konnte. Dieser Keimanstieg regulierte sich auf natürliche Art und Weise und zeigte aber auch deutlich das bevorzugte Klima der Pseudomonaden, die Kälte lieben und auch Gefrierprozesse überleben können.
Bei früheren Untersuchungen ermittelte ich 7 verschiede- und 3 frühere Pseudomonaden in meinem Teichwasser. Mit der aktuellen Identifikation hat sich am Inventar nichts geändert und es kamen keine neuen Namen mehr dazu.
Gruss Dany
Bei früheren Untersuchungen ermittelte ich 7 verschiede- und 3 frühere Pseudomonaden in meinem Teichwasser. Mit der aktuellen Identifikation hat sich am Inventar nichts geändert und es kamen keine neuen Namen mehr dazu.
Gruss Dany
G
Gelöschtes Mitglied 9419
Guest
Episoden des vergangenen Sommers in meinem Teich
Das Futterkorn im Visier, steuert „Chagoi von Wallenried“ entschlossen auf das kleine Häppchen zu um es zu vermahlen. Jedoch wurde seine Rechnung nicht mit „Tancho von Laufental“ gemacht, der ihm die Beute vor den Barteln kapert und wegtaucht.
Das Futterkorn im Visier, steuert „Chagoi von Wallenried“ entschlossen auf das kleine Häppchen zu um es zu vermahlen. Jedoch wurde seine Rechnung nicht mit „Tancho von Laufental“ gemacht, der ihm die Beute vor den Barteln kapert und wegtaucht.
Anhänge
G
Gelöschtes Mitglied 9419
Guest
Koi fressen bekanntlich alles weg was sie finden und je kleiner der Teich ist desto grösser wohl die Chance dazu. Es gab jedoch in meinem Teich ein „Futterkügelchen“, das sich mit einem guten Versteck vehement der Fresslust von 8 Koi wiedersetzte und schlussendlich einsam dahinmoderte.
Anhänge
G
Gelöschtes Mitglied 9419
Guest
Auf der anderen Seite erstaunlich wie andere entlegenste und gestrandete Pellets doch wieder erspäht werden. So ist Sanke ein wahrer Kämpfer mit einem gewaltigen Durchhaltevermögen. Nach dieser Aktion war ich mir nicht mehr ganz sicher ob Karpfen vielleicht einmal Landtiere waren. Zwar erreicht dieser Koi das „Kügelchen“ nicht am selben Tag aber am folgenden kam er zurück und liess nicht locker bis es ihm gelang, die Beute hinein zu schmatzen.
Anhänge
G
Gelöschtes Mitglied 9419
Guest
Wenn die „Jagd“ zu Ende ist schwimmt man gemütlich in der Gruppe, wärmt die Flossen in der Sonne, begibt sich zum Sprudelbad oder formt Schatten, die der Fantasie des Koiverückten zu Gute kommen.
Anhänge
G
Gelöschtes Mitglied 9419
Guest
Auch wenn diese Episödchen und Bilder Zufriedenheit der Koi oder vielleicht etwas artgerechtes Dasein vorgaukeln, so wird diese „heile Welt“ zwei Mal jährlich von mir durch unattraktive und vielleicht auch etwas provokative Spülungen der Pflanzenzone getrübt.
Diese „Blumenbeete“ sehe ich im Normalbetrieb nicht als Gefahrenzone für irgendwelche bakterielle Probleme. Hebt man aber diese Büsche an, wird das Schlaraffenland für Kleingetier wie z.B. Wasserasseln oder eben Bakterien sichtbar. Um im Stillen nicht einer Bakterienpopulation die alleinige Herrschaft zu überlassen, bin ich der Meinung dass solche Zonen im Teich gestört werden müssen.
Zwar gelingt es mir manchmal einen Teil dieser Suppe, die mit über 100‘000 KBE/ml und zum Teil noch höher belastet ist, mit dem Teichsauger abzufangen aber eben nur manchmal. Auch mögen die Fische den Aufenthalt in dieser Brühe und pfeifen auf die Keimzahl. Ihnen ist das aufgetischte Buffet mit Kleingetier in diesem Moment viel wichtiger und dies finde ich auch gut so.
Meine Koi müssen jeweils eine gute Stunde in dieser Brühe verweilen. Die Erfahrung an meinem Teich hat gezeigt, dass ich mit sofortigem TWW von 30% und anschliessender UV-Bestrahlung die Keimzahl wieder auf die üblichen Werte einstellen kann.
Wenn ich aber diese Belastungen mit Zahlen nicht sichtbar machen könnte, getraute ich mich nicht solche Spülungen zu tätigen, denn die Möglichkeit einen „Agressor“ freizusetzen ist hier gegeben.
Mit meinen Analysen fühle ich mich bei solchen Tätigkeiten jedoch auf der sicheren Seite aber eben, ich schreibe ja nur von „fühlen“.
Sicher sind jedoch die Vorteile solcher regelmässigen GKZ – Erfassungen. Denke ich zurück an meine gesteigerte Futtervermenge mit „Power“, ich hätte mich ohne Wissen der Keimzahlen wohl weiter am Appetit der Koi und am klaren Wasser erfreut, bis ich mit grosser Wahrscheinlichkeit eher früher als später auf die Front geflogen wäre.
Diese „Blumenbeete“ sehe ich im Normalbetrieb nicht als Gefahrenzone für irgendwelche bakterielle Probleme. Hebt man aber diese Büsche an, wird das Schlaraffenland für Kleingetier wie z.B. Wasserasseln oder eben Bakterien sichtbar. Um im Stillen nicht einer Bakterienpopulation die alleinige Herrschaft zu überlassen, bin ich der Meinung dass solche Zonen im Teich gestört werden müssen.
Zwar gelingt es mir manchmal einen Teil dieser Suppe, die mit über 100‘000 KBE/ml und zum Teil noch höher belastet ist, mit dem Teichsauger abzufangen aber eben nur manchmal. Auch mögen die Fische den Aufenthalt in dieser Brühe und pfeifen auf die Keimzahl. Ihnen ist das aufgetischte Buffet mit Kleingetier in diesem Moment viel wichtiger und dies finde ich auch gut so.
Meine Koi müssen jeweils eine gute Stunde in dieser Brühe verweilen. Die Erfahrung an meinem Teich hat gezeigt, dass ich mit sofortigem TWW von 30% und anschliessender UV-Bestrahlung die Keimzahl wieder auf die üblichen Werte einstellen kann.
Wenn ich aber diese Belastungen mit Zahlen nicht sichtbar machen könnte, getraute ich mich nicht solche Spülungen zu tätigen, denn die Möglichkeit einen „Agressor“ freizusetzen ist hier gegeben.
Mit meinen Analysen fühle ich mich bei solchen Tätigkeiten jedoch auf der sicheren Seite aber eben, ich schreibe ja nur von „fühlen“.
Sicher sind jedoch die Vorteile solcher regelmässigen GKZ – Erfassungen. Denke ich zurück an meine gesteigerte Futtervermenge mit „Power“, ich hätte mich ohne Wissen der Keimzahlen wohl weiter am Appetit der Koi und am klaren Wasser erfreut, bis ich mit grosser Wahrscheinlichkeit eher früher als später auf die Front geflogen wäre.
Anhänge
G
Gelöschtes Mitglied 9419
Guest
Nun, voraussichtlich wird in einem Monat die Wassertemperatur in ungeheizten Teichen wieder leicht höher 10°C sein und wieder 30 Tage später annähernd die 20°C Marke erreicht haben. Leider steigen nicht nur die Temperaturen sondern mit ihnen auch der Keimdruck im Wasser der Ende April, je nach Ausgangslage bereits um das 10-fache höher sein wird als zur jetzigen Zeit.
Hoffen wir für unsere Fische dass weiterhin die Sonne scheint und sie auch im kommenden Sommer wieder ein unbelastetes Dasein geniessen dürfen.
Gruss Dany
Hoffen wir für unsere Fische dass weiterhin die Sonne scheint und sie auch im kommenden Sommer wieder ein unbelastetes Dasein geniessen dürfen.
Gruss Dany
Anhänge
G
Gelöschtes Mitglied 9419
Guest
Relationen von Keimbelastungen
Ich fand wieder einmal einen Artikel einer schweizer Konsumenten – Zeitschrift. (Saldo 17 / 2009 vom 20.Oktober.2009)
Folgend einige Ausschnitte daraus.
Genau gleich verhält es sich bei unserem Teichwasser wo wir bis auf den Grund sehen. Die Keimbelastung ist meist nicht zu sehen oder zu riechen und erst erkennbar wenn der Koi mit atypischem Verhalten oder Veränderungen seiner Haut Zeichen setzt. Mit Dip Slides ist man jedoch einen Schritt voraus.
Ein gut geführter Koiteich weist eine GKZ bis zu 30‘000 KBE/ml auf und hat eine Durchschnittszahl der Enterobakterien (Ermittlung aus 24 Teichen) von 700 KBE/ml.
Gruss Dany
Ich fand wieder einmal einen Artikel einer schweizer Konsumenten – Zeitschrift. (Saldo 17 / 2009 vom 20.Oktober.2009)
Folgend einige Ausschnitte daraus.
Eklig in der Vorstellung ist die Tatsache, dass sich solche bakterielle Verunreinigungen nicht unbedingt „heraus schmecken oder riechen“ lassen und wir nicht wirklich wissen, welche „Kacke“ wir manchmal in der Bratpfanne entkeimen und später genüsslich verspeisen.- Fischfilets im Offenverkauf: Viel zu viele Keime und Bakterien.
Saldo liess 30 Fischfilets aus dem Offenverkauf untersuchen. Das erschreckende Resultat: Nur eine Probe war einwandfrei.
- Jeder zweite Fisch hatte eine zu hohe Gesamtkeimzahl. Die Rotzunge vom…………und die Flunder vom…………wiesen über 100 Millionen Keime pro Gramm auf. Gar 224 Millionen keime pro Gramm fand das Labor beim Goldbutt aus dem……………Basel. Dieser Wert ist 448-mal höher als der Richtwert der deutschen Gesellschaft für Hygiene und Mikrobiologie DGHM.
- 13 Fische überschritten den Richtwert für Enterobakterien. Fünf Proben lagen deutlich über dem Warnwert von 100‘000 Darmbakterien pro Gramm.
- Die Qualität der Fische entspricht nicht annähernd den Erwartungen der Konsumenten, die mitunter hohe Preise für „frischen“ Fisch bezahlen. Immerhin: Bei starkem Erhitzen sterben die Keime in der Regel ab, was eine Gesundheitsgefährdung ausschliesst. Allerdings müssen die Fische sorgfältig durchgegart sein.
Genau gleich verhält es sich bei unserem Teichwasser wo wir bis auf den Grund sehen. Die Keimbelastung ist meist nicht zu sehen oder zu riechen und erst erkennbar wenn der Koi mit atypischem Verhalten oder Veränderungen seiner Haut Zeichen setzt. Mit Dip Slides ist man jedoch einen Schritt voraus.
Ein gut geführter Koiteich weist eine GKZ bis zu 30‘000 KBE/ml auf und hat eine Durchschnittszahl der Enterobakterien (Ermittlung aus 24 Teichen) von 700 KBE/ml.
Gruss Dany
G
Gelöschtes Mitglied 9419
Guest
Wenn ich meine Zeit im früheren schweizer Koi-Forum dazu zähle, so sind es sechs Jahre in denen ich mich für die selbständige Ermittlung der Gesamtkeimzahl in Koiteichen einsetze. Ein wichtiger Wert um Veränderungen des Keimdruckes im Teichwasser zu erkennen. Für mich nach wie vor immer noch eine wichtige Sache wenn es um die Gesundheit von Koi geht.
Wenn heute von Keimdruck im Teichwasser gesprochen wird, kann dessen Höhe mit Zahlen beschrieben werden. Schwammige Aussagen wie: „In meinem Teich habe ich einen hohen Keimdruck!“ oder meine Fische haben keine Rötungen mehr, der Keimdruck ist nun tief!“ sollten der Vergangenheit angehören.
Tauchnährböden sind nichts Neues und ich habe diese vor Jahren lediglich wieder hervorgeholt um ihre Möglichkeiten zur Keimbestimmung etwas genauer aufzuzeigen. Zugegeben, nicht leichte Überzeugungsarbeit aber die Tatsache dass ich einen Thread über 46 Seiten führen durfte ohne von den „Foren-Profis“ zerrissen zu werden, zeigt doch dass hier nicht irgend ein Müll geschrieben wurde.
Auch die Nennung in Dr. Sandra Lechleiters FISHCARE, die Mitwirkung meiner Daten in ihrem Webinar und ihre äusserst nette Beschenkung zu Weihnachten, bestätigten mir dass ich mit meinem Engagement für die Ermittlung der GKZ in Koiteichen auf einem nicht nur interessanten sondern auch enorm wichtigen Weg zum Wohlergehen von Koi bin.
Dass ich in diesem Thread mit eigenen Resultaten von Analysen aus meinem Teich und anderen Gewässern berichten konnte, freut mich besonders. Dies verdanke dem Vorgesetzten an meinem Arbeitsplatz, der mir nahelegte, mich nicht an end- und zum Teil sinnlosen wie manchmal auch überheblichen Forendiskussionen zu beteiligen. Er sagte zu mir:
„Dany, um zu sehen wie es tut musst du machen!“
Dies habe ich über Jahre gemacht und werde es auch weiterhin tun aber nicht in der Öffentlichkeit. Dass ein hoher Keimdruck Koi krank macht oder dass bei einer tiefen Keimzahl der Fisch weniger Stresshormone freigibt haben Fischärzte längst bewiesen. Ich kann an dieser Stelle nichts mehr bewegen und alle paar Wochen Wiederholungen oder irgendwelche Episoden einstellen bringt nichts.
Aus diesem Grund ziehe ich mich zurück und hoffe dass „Keimzahlen im Koiteich“ durch meinen Abgang nicht zum Sterben verurteilt wird.
Ich wünsche nun allen User nur das Beste und jedem einzelnen genügend Wille und Energie um seinen Koi Gutes zu tun und bedanke mich gleichzeitig mit Fotos aus meinem Teich die mir besonders gut gefallen, für den fairen Austausch in diesem Forum.
Tschau zäme ond möchids guet
Dany

Wenn heute von Keimdruck im Teichwasser gesprochen wird, kann dessen Höhe mit Zahlen beschrieben werden. Schwammige Aussagen wie: „In meinem Teich habe ich einen hohen Keimdruck!“ oder meine Fische haben keine Rötungen mehr, der Keimdruck ist nun tief!“ sollten der Vergangenheit angehören.
Tauchnährböden sind nichts Neues und ich habe diese vor Jahren lediglich wieder hervorgeholt um ihre Möglichkeiten zur Keimbestimmung etwas genauer aufzuzeigen. Zugegeben, nicht leichte Überzeugungsarbeit aber die Tatsache dass ich einen Thread über 46 Seiten führen durfte ohne von den „Foren-Profis“ zerrissen zu werden, zeigt doch dass hier nicht irgend ein Müll geschrieben wurde.
Auch die Nennung in Dr. Sandra Lechleiters FISHCARE, die Mitwirkung meiner Daten in ihrem Webinar und ihre äusserst nette Beschenkung zu Weihnachten, bestätigten mir dass ich mit meinem Engagement für die Ermittlung der GKZ in Koiteichen auf einem nicht nur interessanten sondern auch enorm wichtigen Weg zum Wohlergehen von Koi bin.
Dass ich in diesem Thread mit eigenen Resultaten von Analysen aus meinem Teich und anderen Gewässern berichten konnte, freut mich besonders. Dies verdanke dem Vorgesetzten an meinem Arbeitsplatz, der mir nahelegte, mich nicht an end- und zum Teil sinnlosen wie manchmal auch überheblichen Forendiskussionen zu beteiligen. Er sagte zu mir:
„Dany, um zu sehen wie es tut musst du machen!“
Dies habe ich über Jahre gemacht und werde es auch weiterhin tun aber nicht in der Öffentlichkeit. Dass ein hoher Keimdruck Koi krank macht oder dass bei einer tiefen Keimzahl der Fisch weniger Stresshormone freigibt haben Fischärzte längst bewiesen. Ich kann an dieser Stelle nichts mehr bewegen und alle paar Wochen Wiederholungen oder irgendwelche Episoden einstellen bringt nichts.
Aus diesem Grund ziehe ich mich zurück und hoffe dass „Keimzahlen im Koiteich“ durch meinen Abgang nicht zum Sterben verurteilt wird.
Ich wünsche nun allen User nur das Beste und jedem einzelnen genügend Wille und Energie um seinen Koi Gutes zu tun und bedanke mich gleichzeitig mit Fotos aus meinem Teich die mir besonders gut gefallen, für den fairen Austausch in diesem Forum.
Tschau zäme ond möchids guet
Dany
Anhänge
G
Gelöschtes Mitglied 9419
Guest
Hallo dänu,
Das wäre sehr schade wenn du dich jetzt zurückziehst. Ich habe deine Beiträge sehr gerne gelesen, deine Ideen mit eingesetzt und finde du hast was großes geschaffen.
Ich würde mich freuen auch in Zukunft von dir weiter mit Informationen versehen zu werden,da du ganz offensichtlich einer der wenigen in diesem Segment von Fachleuten bist.
Das wäre sehr schade wenn du dich jetzt zurückziehst. Ich habe deine Beiträge sehr gerne gelesen, deine Ideen mit eingesetzt und finde du hast was großes geschaffen.
Ich würde mich freuen auch in Zukunft von dir weiter mit Informationen versehen zu werden,da du ganz offensichtlich einer der wenigen in diesem Segment von Fachleuten bist.
Ähnliche Themen
- Antworten
- 1
- Aufrufe
- 1K